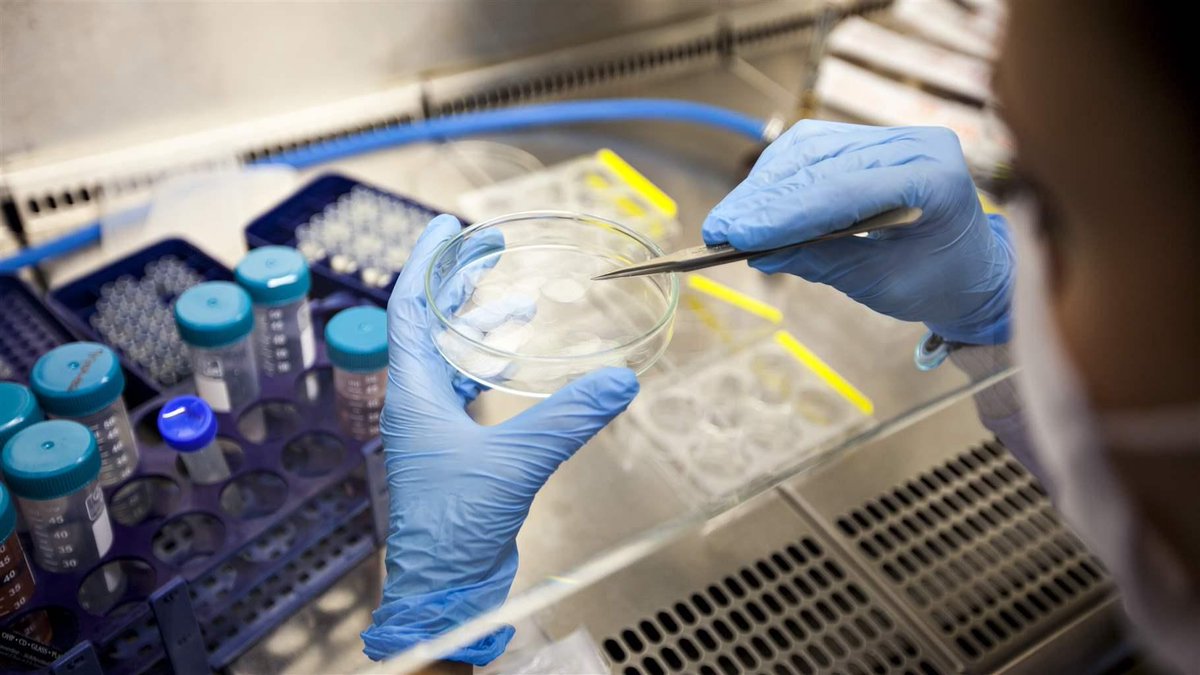
JeffWritingServ's tweet image. Autism, Parkinson's, cerebral palsy, and heart disease ... The #FDA and Congress are tough on claims. Avoid #WarningLetters by reading about how they have #stemcell industry buff.ly/2zkeHWV

#Autism #Parkinsons #CerebralPalsy #HeartDisease

#warningletters Suchergebnisse
#FDA #warningletters are still being issued to #cbdoil companies. Be careful how you market those products! bit.ly/37108vN

CDER warning letters surged 50% in FY 2025 — signaling major shifts in enforcement. #RegulatoryCompliance #CDER #WarningLetters

Autism, Parkinson's, cerebral palsy, and heart disease ... The #FDA and Congress are tough on claims. Avoid #WarningLetters by reading about how they have #stemcell industry buff.ly/2zkeHWV #Autism #Parkinsons #CerebralPalsy #HeartDisease

The #FDA has issued #warningletters to two Chinese active #pharmaceutical ingredient #manufacturers for "significant" deviations from current Good #Manufacturing Practice (#cGMP) and blocked their products from entering the U.S. market. pharmamanufacturing.com/industry-news/… #China #pharma
⚠️FDA Issues #WarningLetters to #breastimplant makers #MENTOR #SIENTRA today 19/3/19 #IMPLANTfiles @Ninad54 @CharleneMelou @laurentgaudon @beuc @EP_Environment @Europarl_EN @EUombudsman @alemannoEU @ansm @MHRAdevices @CommissionerHR @rivm @LV_MPA @TGAgovau bit.ly/2HGXn3x
Have you read this #AssurX blog post analyzing 2017 #FDA #WarningLetters? What type of manufacturer received the majority of warning letters? Find out now! ow.ly/Jhz230iNpFA
For the next instalment of our public inquiries article series, we are looking at Warning Letters. Holly Spencer-Biggs looks at who may receive a warning letter, what it will include and more here: blakemorgan.co.uk/warning-letter… #PublicInquiries #WarningLetters #Rule13
In 2017 what were the top violations in #FDA #WarningLetters? Which type of #manufacturer received the most warning letters? Read the #AssurX blog post to find out! ow.ly/cwDf30inZXk
The #FDA in 2025 has hit several #drugmakers with #warningletters, import alerts, and Form 483s for #manufacturing lapses ranging from #dataintegrity violations to sterility assurance failures. Here are 10 such companies. pharmamanufacturing.com/all-articles/a… #pharmamanufacturing #regulatory
The regular review of Warning Letters received by other manufacturers can be an opportunity for your own improvement – without the negative side effects. link.achesongroup.com/FDA-warning-le… #FDA #WarningLetters #HazardAnalysis

Did you hear the recent news? The @US_FDA has issued out #WarningLetters to 189 for selling unauthorized #TobaccoProducts, such as #ElfBar and #Esco. Both of these brands are #disposable #Ecigarettes that come in #flavors that appeal to #youth. zurl.co/gwG9
Plaintiff attorney advertising in pharmaceutical and medical device litigation: addressing the risk of harm to the public dlapi.pr/bQ1lq2 #FTC #warningletters #scientificevidence #medicaldecisionmaking

#FDA #WarningLetters indicate that #pharma #manufacturers don't have #manufacturing in a state of #cGMP control. Learn 4 ways an automated #quality and #ComplianceManagement system builds control in regard to adulteration and potential contamination now! ow.ly/ZiYh30iUktx
This seminar with Susanne Manz will help you get your #qualitysystem off to a good start and avoid common problems including #MDRs, recalls, 483s, and #warningletters. Signup now! bit.ly/3HbGNUv #PurchasingControls #SupplierManagement

FDA sends warning letters to food firms over seafood violations and Listeria in ready-to-eat facility | Food Safety News foodsafetynews.com/2022/11/fda-se… #FDA #WarningLetters #Seafood #Violatinos
Our unwanted visitor left a total trail of destruction- luckily 5T aren’t faint hearted 🦖👏 #warningletters



#FoodSafety #warningletters issued by the #FDA .
Today we issued warning letters to three infant formula manufacturers, as part of the agency’s ongoing commitment to enhance regulatory oversight to help ensure that the industry is producing infant formula under the safest conditions possible. fda.gov/news-events/pr…

Imported Seafood Safety: FDA Should Improve Monitoring of Its Warning Letter Process and Better Assess Its Effectiveness gao.gov/products/gao-2… @USGAO @FDAfood #FDA #WarningLetters #FloodSafety
FDA #WarningLetters and #Form483 Observations - What’s the Difference? buff.ly/2I8pTfj via @greenlightguru

The #FDA in 2025 has hit several #drugmakers with #warningletters, import alerts, and Form 483s for #manufacturing lapses ranging from #dataintegrity violations to sterility assurance failures. Here are 10 such companies. pharmamanufacturing.com/all-articles/a… #pharmamanufacturing #regulatory
The #FDA in 2025 has hit several #drugmakers with #warningletters, import alerts, and Form 483s for #manufacturing lapses ranging from #dataintegrity violations to sterility assurance failures. Here are 10 such companies. pharmamanufacturing.com/all-articles/a… #pharmamanufacturing #regulatory
Should Stalkers Receive Warning Letters? The Debate #StalkingAwareness #WarningLetters #VictimSupport #LegalDebate #SafetyFirst #CriminalJustice #ProtectiveOrders #CommunityPoll #TrueCrimeDiscussion #Empowerment
Don't miss this Editor's (re)View, where our editors discuss warning letters issued to Indian and Chinese API manufacturers by U.S. regulators. #warningletters #quality #qualityconcerns #API #APImanufacturers #pharmamanufacturing #editorsreview pharmamanufacturing.com/editors-review…
pharmamanufacturing.com
Editor’s (re)View: API makers in China, India flagged by FDA are reminder of ongoing quality...
India’s Global Calcium and China’s Wuhu Nuowei Chemistry and Chengdu Innovation Pharmaceutical are the latest to be hit with warning letters from U.S. regulators.
The FDA has issued warning letters to two Chinese API manufacturers, Wuhu Nuowei Chemistry and Chengdu Innovation Pharmaceutical, for “significant” deviations from cGMP. #FDA #warningletters #API #cGMP #pharmanews #pharmamanufacturing pharmamanufacturing.com/industry-news/…

The #FDA has issued #warningletters to two Chinese active #pharmaceutical ingredient #manufacturers for "significant" deviations from current Good #Manufacturing Practice (#cGMP) and blocked their products from entering the U.S. market. pharmamanufacturing.com/industry-news/… #China #pharma
#WarningLetters issued to #Importers for #FSVP noncompliance can be avoided with TAG’s help! link.achesongroup.com/FSVP-WL #483 #HACCP #ImportedFoods #QI #TAGTraining

Following, FDA warning letters, several homeopathic companies announced they would suspended marketing eye care products. #homeopathy #FDA #warningletters #eyecare #eyedrops #eyecareproducts #eyehealth vitaminretailer.com/homeopathic-co…
vitaminretailer.com
Homeopathic Companies Suspend Marketing of Eye Care Products After Receiving FDA Warning Letters
In September, FDA sent warning letters to eight companies for "manufacturing ophthalmic drug products in violation of federal law...
This article about the #ftc sending #warningletters to #wellness companies like @Goop and @HonestCompany has to do with #wellnessproducts. But, #wellnesspractitioners should take note as well. athletechnews.com/ftc-issues-war…

This article about the #ftc sending #warningletters to #wellness companies like @Goop and @HonestCompany has to do with #wellnessproducts. But, #wellnesspractitioners should take note as well. athletechnews.com/ftc-issues-war…

This article about the #ftc sending #warningletters to #wellness companies like @Goop and @HonestCompany has to do with #wellnessproducts. But, #wellnesspractitioners should take note as well. athletechnews.com/ftc-issues-war…

This article about the #ftc sending #warningletters to #wellness companies like @Goop and @HonestCompany has to do with #wellnessproducts. But, #wellnesspractitioners should take note as well. athletechnews.com/ftc-issues-war…

This article about the #ftc sending #warningletters to #wellness companies like @Goop and @HonestCompany has to do with #wellnessproducts. But, #wellnesspractitioners should take note as well. athletechnews.com/ftc-issues-war…

This article about the #ftc sending #warningletters to #wellness companies like @Goop and @HonestCompany has to do with #wellnessproducts. But, #wellnesspractitioners should take note as well. athletechnews.com/ftc-issues-war…

This article about the #ftc sending #warningletters to #wellness companies like @Goop and @HonestCompany has to do with #wellnessproducts. But, #wellnesspractitioners should take note as well. athletechnews.com/ftc-issues-war…

The FDA Issues Warning Letters to Three Infant Formula Manufacturers. Check out the full safety alert here: fda.gov/news-events/pr…. #FDA #safety #warningletters
#FoodSafety #warningletters issued by the #FDA .
Today we issued warning letters to three infant formula manufacturers, as part of the agency’s ongoing commitment to enhance regulatory oversight to help ensure that the industry is producing infant formula under the safest conditions possible. fda.gov/news-events/pr…

During the course of the evidence given to an #Inquiry it is inevitable that criticisms will be made of individuals or organisations. #WarningLetters ensure that witnesses or organisations have a fair opportunity to respond to criticism. Read more here: blakemorgan.co.uk/warning-letter…
What are the rules that are set out in warning letters in public inquires? We explain about what is included and who they can be for here: blakemorgan.co.uk/warning-letter… #PublicInquiries #WarningLetters #Rule13
Recently, the @US_FDA issued out #WarningLetters to several #EcigaretteCompanies for selling and distributing unauthorized #EcigaretteProducts that are popular among #youth. Currently, only 23 #TobaccoFlavored #EcigProducts have received authorization. zurl.co/vCjO
After PM @ImranKhanPTI notice, govt issues #WarningLetters to 263 under-performing officers & 7 officers served #ShowCauseNotices. 833 officers were instructed to be #CarefulinFuture and an explanation was sought from 111 others. @GovtofPunjabPK @UsmanAKBuzdar @CSoffice_Punjab

In this seminar with David Nettleton, learn how to use #electronicrecords and signatures to maximize productivity, understand what is expected in Part 11 and Annex 11 inspections, and avoid #fda483 and #Warningletters. Signup Now! bit.ly/2YXCcVD #computersystemvalidation

#FDA #warningletters are still being issued to #cbdoil companies. Be careful how you market those products! bit.ly/37108vN

This seminar with Susanne Manz will help you get your #qualitysystem off to a good start and avoid common problems including #MDRs, recalls, 483s, and #warningletters. Signup now! bit.ly/3HbGNUv #PurchasingControls #SupplierManagement

Device warning letters plunged nearly 90% over 5 years. An FDA official predicts a rebound ow.ly/mieW50xSqu7 #fda #warningletters #medicaldevice #cdrh

Our unwanted visitor left a total trail of destruction- luckily 5T aren’t faint hearted 🦖👏 #warningletters



The regular review of Warning Letters received by other manufacturers can be an opportunity for your own improvement – without the negative side effects. link.achesongroup.com/FDA-warning-le… #FDA #WarningLetters #HazardAnalysis

Autism, Parkinson's, cerebral palsy, and heart disease ... The #FDA and Congress are tough on claims. Avoid #WarningLetters by reading about how they have #stemcell industry buff.ly/2zkeHWV #Autism #Parkinsons #CerebralPalsy #HeartDisease
#WarningLetters issued to #Importers for #FSVP noncompliance can be avoided with TAG’s help! link.achesongroup.com/FSVP-WL #483 #HACCP #ImportedFoods #QI #TAGTraining

This article about the #ftc sending #warningletters to #wellness companies like @Goop and @HonestCompany has to do with #wellnessproducts. But, #wellnesspractitioners should take note as well. athletechnews.com/ftc-issues-war…

Do you want to dodge one of the most frequent reasons for being issued #483s and #Warningletters? Be a part of this exclusive webinar by our Subject Matter Expert Susanne Manz to learn the #techniques of writing an effective and efficient #SOP for #QMS lnkd.in/gXVavkth

Te contamos las #NoConformidades en #SistemasInformatizados #WarningLetters #FDA, y cómo #Prevenir y #Controlar las #Incidencias de la #IntegridadDatos #DataIntegrity ow.ly/2T8W50hcMW8

Struggling with FDA warning letters? Say goodbye to stress and confusion when dealing with #FDA #WarningLetters. Download our guide and get the insider knowledge you need to respond to FDA warnings effectively. Download here >> bit.ly/3JHaRMT #Pharma #ExpertTips

A #Pharma company in India was brought to task due to the actions of a #whistleblower. This led to an increase in #WarningLetters and #audits, putting pressure on organisations. Today's case study focusses on whistleblowers in Indian Pharma. Read more: goo.gl/21W4AJ

FDA posted 12 #warningletters & 3 #advisoryletters to companies illegally selling products making unproven drug claims to prevent, treat/cure #Alzheimers disease. Products are marketed & sold online & on social media without FDA approval. #healthfraud …

DYK ? #FDAORA issues #warningletters to companies that violate FDA regulations. View recent warning letters here: go.usa.gov/x8nSp #youvebeenwarned

FDA #WarningLetters and #Form483 Observations - What’s the Difference? buff.ly/2I8pTfj via @greenlightguru

#FDA has issued hundreds of #483s & #warningletters to #compoundingpharmacies How to respond bit.ly/1SU5A3O

The FDA has issued warning letters to two Chinese API manufacturers, Wuhu Nuowei Chemistry and Chengdu Innovation Pharmaceutical, for “significant” deviations from cGMP. #FDA #warningletters #API #cGMP #pharmanews #pharmamanufacturing pharmamanufacturing.com/industry-news/…

Something went wrong.
Something went wrong.
United States Trends
- 1. #ChilisFoodCourt N/A
- 2. Wonder Woman N/A
- 3. Maxima N/A
- 4. Gallego N/A
- 5. Boasberg N/A
- 6. #gachiakuta165 N/A
- 7. Lena Dunham N/A
- 8. Black Cat N/A
- 9. #Our_7_Are_One_In_A_Billion N/A
- 10. Adria Arjona N/A
- 11. Cade McNamara N/A
- 12. Lonna Drewes N/A
- 13. Lisa Bloom N/A
- 14. #PortfolioDay N/A
- 15. Javier Mascherano N/A
- 16. DoorDash N/A
- 17. #BELIFT_Face_Boycott N/A
- 18. Vin Diesel N/A
- 19. Meloni N/A
- 20. Man of Tomorrow N/A


































